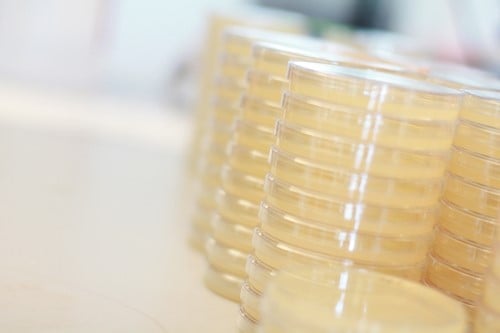
IMG_1073.JPG

Our Mission: To address important biological questions relevant to a broad range of diseases and encompassing multiple levels of biological organization, including an understanding of how different pathogens affect their target organ systems.
Department Chair

Beth A. McCormick, Ph.D. The Worcester Foundation for Biomedical Research Chair. Chair of the Department of Microbiology. Founding director of the Center for Microbiome Research.
Department Vice Chair

Chris Sassetti, Ph.D., Professor and vice-chair of the Department of Microbiology.
Investigators in the Department utilize multidisciplinary approaches that integrate genomic, proteomic, high-resolution imaging, and computational methodologies to characterize networks of host-microbe interactions at the molecular, cellular, and organismal levels.
Read more about the Department of Microbiology here.
Read about Department of Microbiology Research here.